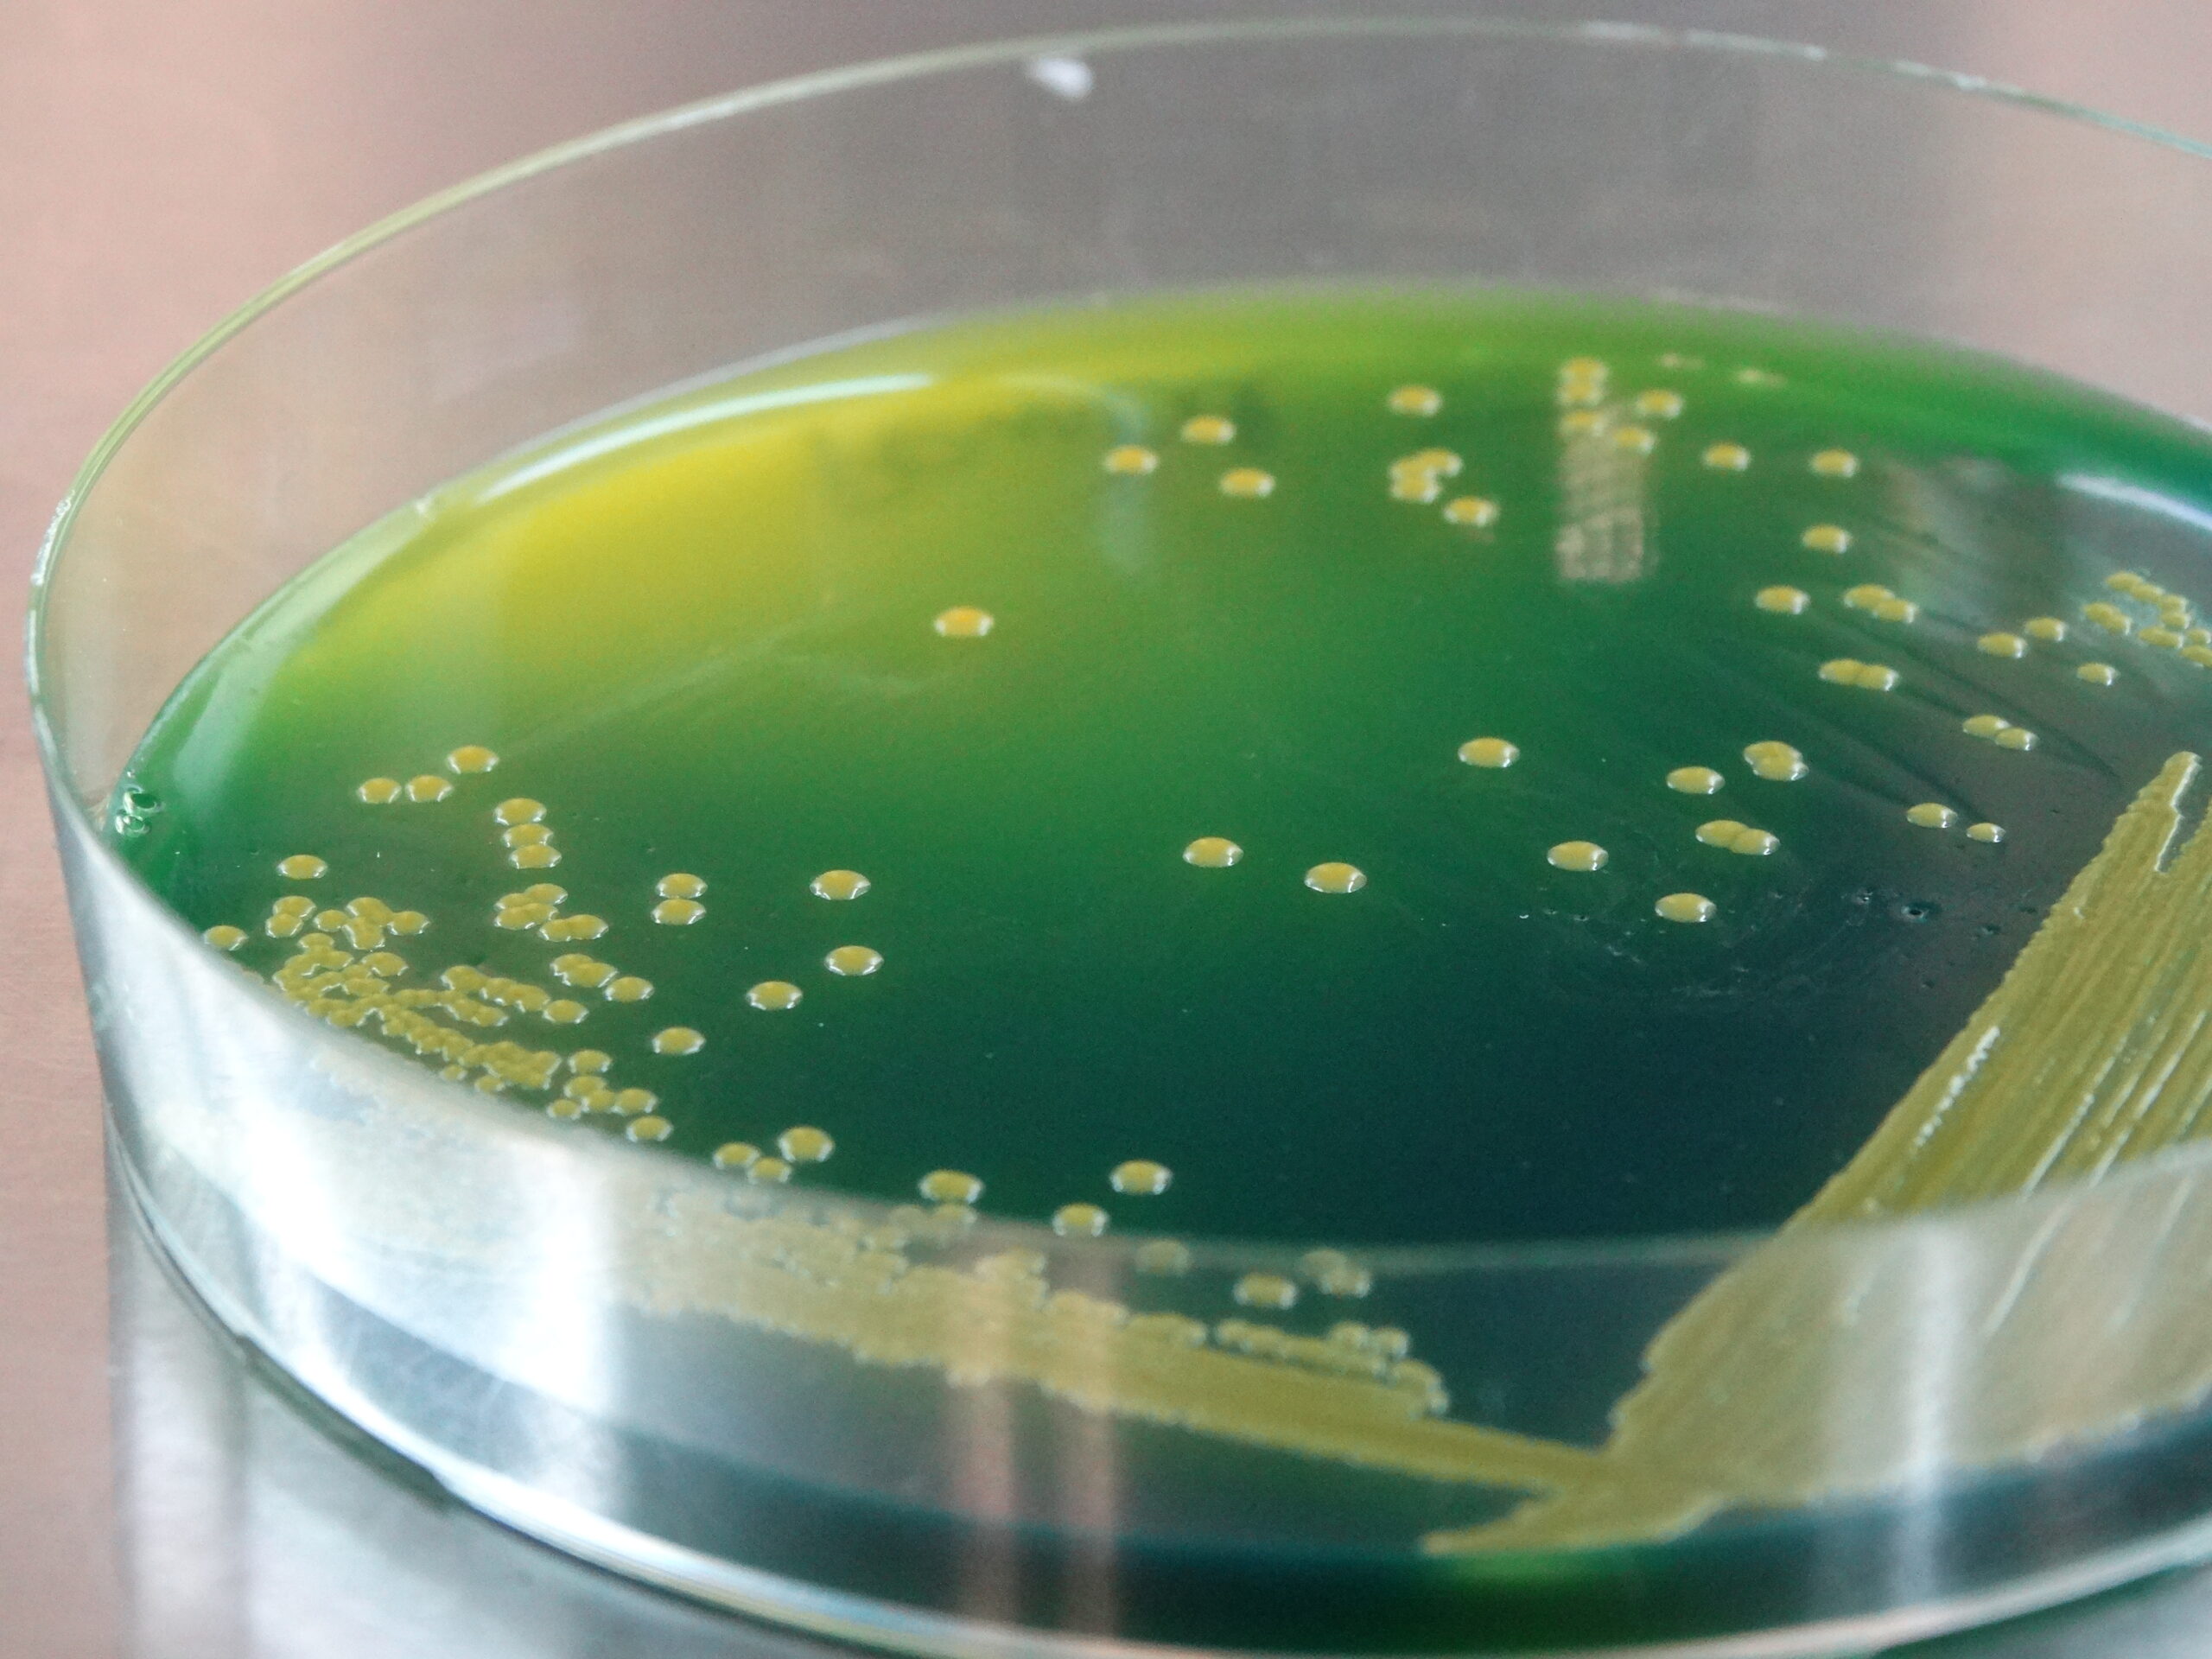
Curso internacional – Introducción a los bioinsumos agrícolas V2

Abr 3, 2024 | eventos, noticias
Taller Desafíos Resolución 9.074/2018 El pasado 2 de abril nuestra Red Chilena de Bioinsumos realizó con mucho éxito el taller Desafíos Resolución 9074/2018. Realizado en el Salón UFRO en Santiago este taller que tuvo como objetivo principal el poder revisar la norma,...

Feb 9, 2024 | eventos, noticias
Capacitación sobre Bioinsumos Agrícolas en Nueva Imperial: Impulso a la Agricultura Sostenible Éxito en la Capacitación sobre Bioinsumos Agrícolas en Nueva Imperial: Impulso a la Agricultura Sostenible Fecha: 20 de Octubre de 2023 En un hito significativo para la...

Feb 9, 2024 | eventos, noticias
VI Conferencia Latinoamericana de Microorganismos Promotores del Crecimiento Vegetal En el marco del XXXI Congreso RELAR (Reunión Latinoamericana de Rizobiología) y la VI Reunión de Promotores del Crecimiento Vegetal (PGPR), organizados por la Corporación de...

May 27, 2023 | jornadas, noticias
Seminario abierto – Mayo 2023 Durante el pasado 11 de mayo se realizó un nuevo seminario abierto, en formato híbrido donde se pudo revisar el resultado de investigación de Xiomara Campos, con su tesis “BIOINSUMOS EN BASE A INOCULANTES MICROBIANOS:...